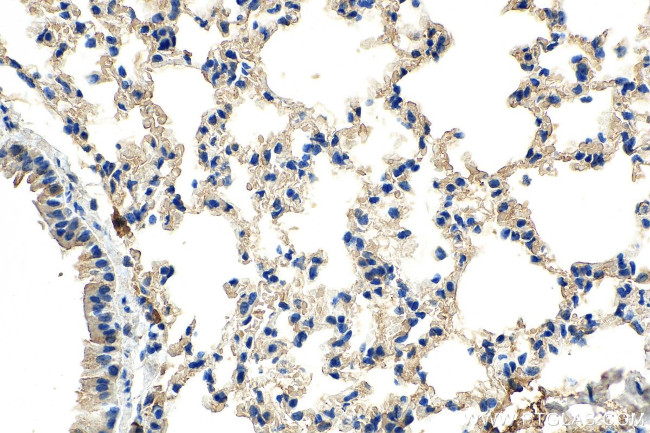
SERPINB9 Antibody in Immunohistochemistry (Paraffin) (IHC (P))

Search
Proteintech
SERPINB9 Monoclonal Antibody (2H9D2)
{{$productOrderCtrl.translations['antibody.pdp.commerceCard.promotion.promotions']}}
{{$productOrderCtrl.translations['antibody.pdp.commerceCard.promotion.viewpromo']}}
{{$productOrderCtrl.translations['antibody.pdp.commerceCard.promotion.promocode']}}: {{promo.promoCode}} {{promo.promoTitle}} {{promo.promoDescription}}. {{$productOrderCtrl.translations['antibody.pdp.commerceCard.promotion.learnmore']}}
产品信息
67950-1-IG150UL
种属反应
宿主/亚型
分类
类型
克隆号
偶联物
形式
浓度
规格
纯化类型
保存液
内含物
保存条件
运输条件
靶标信息
PI9 belongs to the large superfamily of serine proteinase inhibitors (serpins), which bind to and inactivate serine proteinases. These interactions are involved in many cellular processes, including coagulation, fibrinolysis, complement fixation, matrix remodeling, and apoptosis (Sprecher et al., 1995 [PubMed 8530382]).
仅用于科研。不用于诊断过程。未经明确授权不得转售。
篇参考文献 (0)
生物信息学
蛋白别名: CAP-3; Cytoplasmic antiproteinase 3; Peptidase inhibitor 9; PI-9; protease inhibitor 9 (ovalbumin type); serine (or cysteine) proteinase inhibitor, clade B (ovalbumin), member 9; serine (or cysteine) proteinase inhibitor, clade B, member 9; serine protease inhibitor 6; Serpin B9; serpin peptidase inhibitor, clade B (ovalbumin), member 9; serpin peptidase inhibitor, clade B, member 9; SERPINB9; testicular tissue protein Li 180; unnamed protein product
基因别名: BB283241; CAP-3; CAP3; ovalbumin; PI-9; PI9; SERPINB9; Spi6
UniProt ID: (Human) P50453
Entrez Gene ID: (Human) 5272, (Mouse) 20723